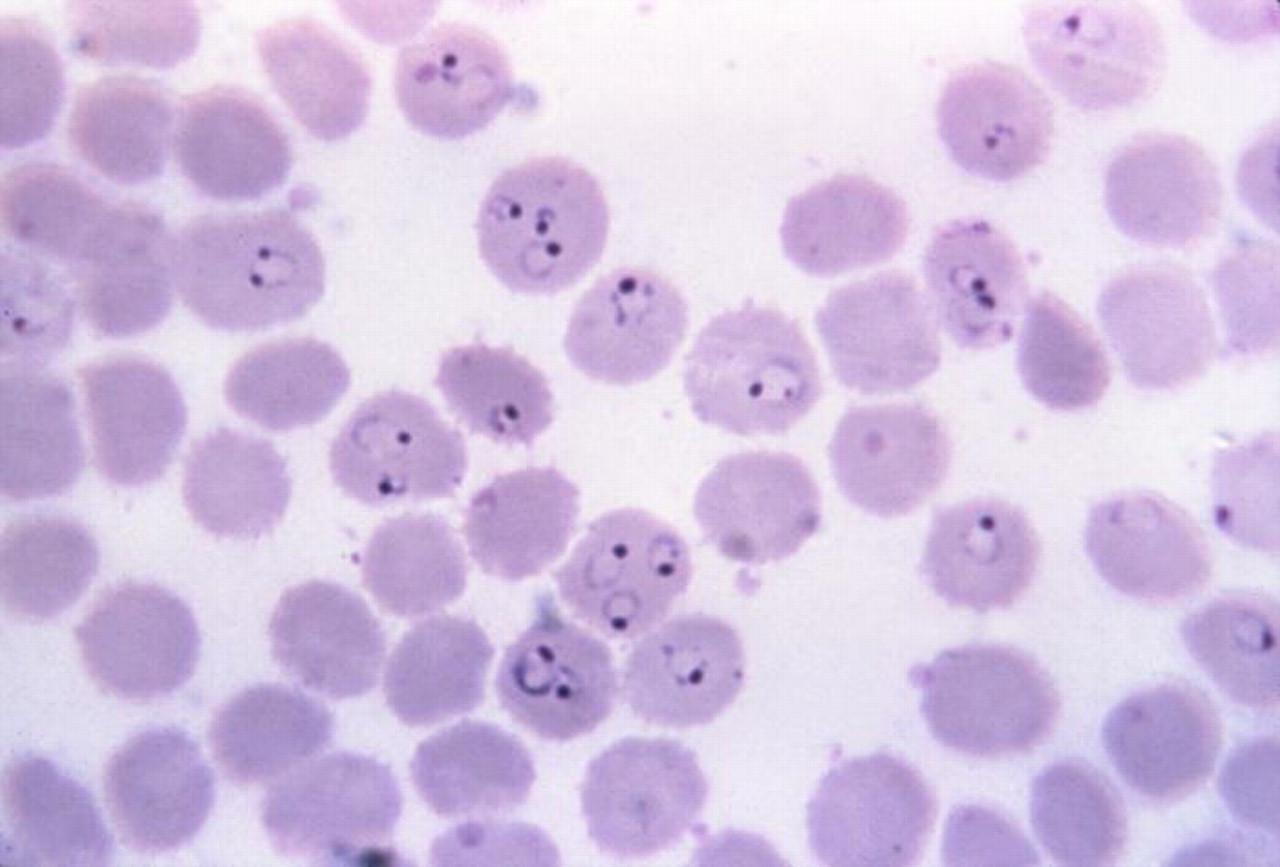
WHAT IS INTELLIGENCE? HUMAN Vs PARASITE. PLASMODIUM FALCIPARUM, PROTOZOAN PARASITE THAT CAUSES MALARIA, SEEN IN RED BLOOD CELLS OF INFECTED HOST.

WHAT IS INTELLIGENCE? MAN Vs PARASITE

Nobel Medal is awarded to people in recognition of their contributions for the greatest benefit to mankind and Nobel Prize symbolizes human intellectual achievement. What about Viruses, Bacteria, Protozoa, and other simpler forms of life? Do they have Intelligence?

Three scientists have shared 2015 Nobel Prize in Physiology or Medicine for discovering therapeutic interventions to fight battle against parasites that cause death and disability among people of over 26 nations of our world. 200+ million cases of Malaria are reported per year and Malaria contributes to about one million deaths each year. Malaria is the fifth-most likely cause of death in several countries. How to recognize ability of a parasite which keeps responding to human interventions that aim to affect its survival?



This Nobel Prize Award recognizes importance of problems posed by lower-forms of life called ‘PARASITES’ and these parasites are transmitted to man by agents called ‘vectors’ such as flies and mosquitoes. Man is facing a huge intellectual challenge and a heavy financial burden to defend his mortal existence from attacks by simple organisms. This warfare against parasites and their insect vectors poses the question, ‘What is Intelligence?’ To win this battle, man has to interpret Human Intelligence and may have to acknowledge the fact of ‘Parasite Intelligence’.
WHAT IS INTELLIGENCE?

The term ‘Intelligence’ involves special abilities like cognition(knowing) the ability characterized by possession of knowledge, perception, discernment, ability to learn or understand from experience, ability to acquire and retain knowledge, ability to respond quickly and successfully to a new situation, use of the faculty of reason in solving problems, directing conduct etc., effectively with cleverness, shrewdness to perform tasks to achieve a predetermined goal.
In common usage, Intelligence refers to all-around effectiveness of an individual’s mental processes, particularly capabilities for comprehension, learning, recall, thinking, and reasoning. Intelligence is conceived as innate “BRAINPOWER”(intellectual power) that which distinguishes the more highly evolved animals from simpler organisms and distinguish geniuses from average persons. Originally, Intelligence was conceived of as a unitary power or faculty of mind. Now, Intelligence is viewed as a collection of a large number of highly varied, although overlapping skills rather than as a single faculty. Intelligence may include 120 specific abilities such as verbal, spatial, inductive, numerical, memorizing and reasoning abilities.
Intelligence is thought of behavioral or operational function. Intelligent behavior involves cognition and communication. Psychologists may explain Intelligence as highly coordinated thinking that establishes relationship between creative and analytical thought. Psychologists and Physiologists may view Intelligence as combination of innate characteristics of an individual’s Central Nervous System which is molded by experience, learning, and environmental factors. Intelligence is innate cognitive ability that is modified by upbringing, experience and education.
Philosophers describe Intelligence as multidimensional and in essence it is stated as the abstract faculty that apprehends the conceptual and perceptual relations among objects.
The definition of Intelligence by Psychologists, Philosophers, and various writers as mental ability or faculty of mind and brain does not include an understanding of its purpose. Biologists view Intelligence as a powerful tool of ‘adaptation’ and survival. Intelligence is the ability that is reflected in reproductive success and survival of a living entity. Biologists may have to view Intelligence as the characteristic of all living cells and living organisms. Living functions primarily involve cognitive abilities and use of knowledge or knowing a broad range of information to perform guided, sequential, goal-oriented, and purposeful actions. On contrast, non-living matter has no Intelligence. Intelligence is the ability of living matter/living things to know information, process information and perform functions using both innate and acquired information.

The potentiality or capacity of Intelligence has a biological basis. The primary concern of Intelligence is that of its biological role in supporting existence of the living thing that possesses Intelligence. The Laws of Physical or Natural Sciences operate in world in which all organisms exist. Intelligence is the ability to exploit Natural Laws for material benefit of the living, intelligent entity. Physical Systems do not apply Intelligence in their own operations whereas a Living System uses Intelligence to preserve, to sustain and to promote its own living condition under varied, external conditions.

The fact that Viruses, Bacteria, Protozoa and other Parasites cause death and disability affecting billions of human beings across the world will permit us to acknowledge Intelligence as a biological characteristic ability found in all living entities. The problem of ‘DRUG-RESISTANCE’ exhibited by Malarial parasite and Mosquitoes has to be interpreted as ‘Intelligent Behavior’. Currently, scientists use the term ‘mutation’ to account for drug resistance. Mutations are random, spontaneous, unguided, and purposeless events. The correct term would be ‘ADAPTATION’ which means a change in structure, function, or form that improves chance of survival for an organism within a given environment. Malarial parasite is demonstrating its ability called adaptation when chemical substances are introduced into its environment. Malarial parasite is able to change its metabolic pathways to improve its chances of survival. Parasites have no access to schools or research institutions to learn new skills to respond to changes in environment. Intelligence is innate ability to effectively respond to changes and man has to learn that he is confronting an intelligent enemy.
While paying my humble tribute to these three scientists, I would like to share some information on Biotic Interactions.
BIOTIC COMMUNITY AND BIOTIC INTERACTIONS
A biological or biotic community consists of two or more interacting and interdependent populations of living organisms. The life of the community and of all organisms in it requires energy. No species lives in isolation from other species in a biological or biotic community. Two kinds of Biotic Interactions are described; 1. Intraspecific Biotic Interactions between members of the same species, and 2. Interspecific Biotic Interactions between members of two or more different species. Biotic Interactions may involve nutritional benefits, space in which to live, shelter, or protection, transport, or reproductive capability. Biotic Interactions are significant not only because they influence individual species but also because they constitute the principal stabilizing connective linkages among various species contained in a biotic community. Individual members of any given species in a biotic community persist in relative harmony because of Biotic Interactions despite individual gains and losses. As consequence of this web of interactions, the biotic community as a whole persists with all of its members ultimately contributing to its continuation.
HUMAN BODY AS A BIOTIC COMMUNITY
Human body consists of about 100 trillion independent, individual, living cells. Human body carries about ten times(10 times 100 trillion) as many microorganisms in the gastrointestinal tract. Man has to be always recognized as a natural host of a diverse biotic community. The microbes that colonize man often perform functions beneficial to the host. Man provides microbes a protected place to live and an environment that is rich in nutrients. This mutual beneficial relationship is always present during the entire course of life after birth.
MUTUALISM, COMMENSALISM, AND PARASITISM
Mutualism or Symbiosis describes Biotic Interactions with mutual advantage to both or all organisms involved. It is living together of two kinds of organisms and such association is of mutual advantage. Commensalism describes Biotic Interactions that involve a close association or union between two kinds of organisms in which one is benefited by the relationship and the other is neither benefited nor harmed. The term ‘Parasite’ is used to describe a plant or animal that lives on or in an organism of another species from which it derives sustenance or protection without benefit to, and usually with harmful effects on the host. Thus Parasitism is a Biotic Interaction in which the parasite is benefited and the host is usually harmed with serious consequences. There are numerous parasites that contribute to human pain, misery, and suffering. Onchocerciasis is a fly transmitted tropical disease in which parasitic filarial worms(Genus. Onchocerca) cause tumors, skin lesions, and blindness(River Blindness). Lymphatic Filariasis is caused by another genus of roundworm or nematode. Malaria is an infectious disease, generally intermittent and recurrent, caused by Protozoans(Genus. Plasmodium) that are parasitic in human Red Blood Cells and are transmitted by the bite of an infected mosquito, especially the female Anopheles. Malaria is characterized by severe chills and fever. Plasmodium parasite is a formidable enemy to man’s existence. A medical historian described the proboscis of female Anopheline Mosquito, “Down this tiny tube crept the microscopic poison which swept away two of the mightiest empires the world has ever seen.”
SPIRITUAL BIOTIC INTERACTIONS
The term ‘Spiritual’ describes the nature of relationship, partnership, association, bonding, connection, or Biotic Interaction between two living entities based upon characteristics such as compassion, kindness, sympathy, cooperation, voluntary assistance, mutual tolerance, voluntary subservience, functional subordination, or ‘altruism’ to provide some benefit to another member participating in the Biotic Interaction.
Rudranarasimham Rebbapragada
Ann Arbor, MI 48104-4162, USA
BHAVANAJAGAT.ORG